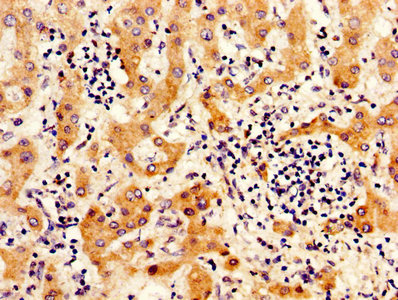
CSB-PA011897LA01HU

ITIH4
ITIH4,全稱為inter-alpha-trypsin inhibitor heavy chain 4,是一種參與炎癥反應的II型急性期蛋白,也被稱為PK120、Gp120、ITIHL1、ITI-HC4等。該蛋白在創傷引起的炎癥反應中發揮作用,可能參與肝臟的發育或再生過程。研究表明,ITIH4蛋白在慢性阻塞性肺疾病(COPD)患者的血清中含量低于健康人,且與空氣污染物的關聯性較高。此外,ITIH4蛋白還可能成為預測COPD病情進展的生物標志物,為評估治療效果提供依據。在藥物研發方面,ITIH4蛋白已被關注,有望成為開發新型治療COPD等疾病藥物的重要靶點。
熱銷產品
Recombinant Human Inter-alpha-trypsin inhibitor heavy chain H4 (ITIH4), partial (CSB-EP617923HU)
驗證數據

(Tris-Glycine gel) Discontinuous SDS-PAGE (reduced) with 5% enrichment gel and 15% separation gel.
ITIH4 Antibody (CSB-PA011897LA01HU)
驗證數據

IHC image of CSB-PA011897LA01HU diluted at 1:300 and staining in paraffin-embedded human liver tissue performed on a Leica BondTM system. After dewaxing and hydration, antigen retrieval was mediated by high pressure in a citrate buffer (pH 6.0). Section was blocked with 10% normal goat serum 30min at RT. Then primary antibody (1% BSA) was incubated at 4°C overnight. The primary is detected by a biotinylated secondary antibody and visualized using an HRP conjugated SP system.
IHC image of CSB-PA011897LA01HU diluted at 1:300 and staining in paraffin-embedded human liver cancer performed on a Leica BondTM system. After dewaxing and hydration, antigen retrieval was mediated by high pressure in a citrate buffer (pH 6.0). Section was blocked with 10% normal goat serum 30min at RT. Then primary antibody (1% BSA) was incubated at 4°C overnight. The primary is detected by a biotinylated secondary antibody and visualized using an HRP conjugated SP system.
ITIH4 Antibodies
ITIH4 for Homo sapiens (Human)
| 產品貨號 | 產品名稱 | 種屬反應性 | 應用類型 |
|---|---|---|---|
| CSB-PA011897LA01HU | ITIH4 Antibody | Human | ELISA, IHC |
| CSB-PA011897LB01HU | ITIH4 Antibody, HRP conjugated | Human | ELISA |
| CSB-PA011897LD01HU | ITIH4 Antibody, Biotin conjugated | Human | ELISA |
| CSB-PA011897YA01HU | ITIH4 Antibody | Human | ELISA, IHC |
| CSB-PA011897YD01HU | ITIH4 Antibody, Biotin conjugated | Human | ELISA |
| CSB-PA011276 | Cleaved-ITIH4 (R661) Antibody | Human | IHC, ELISA |
ITIH4 Proteins
ITIH4 Proteins for Homo sapiens (Human)
| 產品貨號 | 產品名稱 | 來源 |
|---|---|---|
| CSB-YP617923HU | Recombinant Human Inter-alpha-trypsin inhibitor heavy chain H4 (ITIH4),partial | Yeast |
| CSB-EP617923HU | Recombinant Human Inter-alpha-trypsin inhibitor heavy chain H4 (ITIH4), partial | E.coli |
| CSB-BP617923HU CSB-MP617923HU CSB-EP617923HU-B |
Recombinant Human Inter-alpha-trypsin inhibitor heavy chain H4 (ITIH4),partial | Baculovirus Mammalian cell In Vivo Biotinylation in E.coli |
ITIH4 ELISA Kit
ITIH4 ELISA Kit for Homo sapiens (Human)
| 產品貨號 | 產品名稱 | 樣本類型 | 靈敏度 |
|---|---|---|---|
| CSB-E17022h | Human Inter-alpha-trypsin inhibitor heavy chain H4(ITIH4/IHRP/ITIHL1/PK120/PRO1851)ELISA kit | serum, plasma, tissue homogenates | 0.156 ng/mL |












